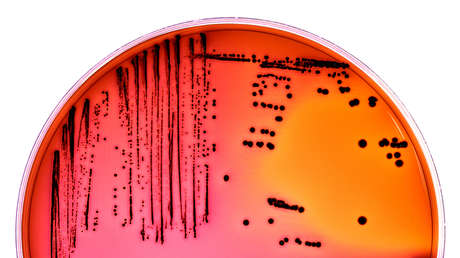
Detectan bacterias resistentes a antibióticos en el suelo y aguas contaminadas en México

Un grupo de investigadores de la Universidad Nacional Autónoma de México (UNAM) ha encontrado una cepa de la bacteria Escherichia coli ('E. coli') en el agua y suelo en el estado mexicano de Hidalgo.
La contaminación se debería a las aguas residuales utilizadas para la agricultura. La investigadora del Instituto de Ciencias de la Atmósfera y Cambio Climático, Irma Aurora Rosas Pérez, quien dirigió el estudio, explicó que para el análisis se tomaron muestras de un lugar que recibe aguas servidas provenientes de Ciudad de México.
Los resultados mostraron que las aguas residuales sobrepasan los límites permitidos en las normas oficiales mexicanas, 1.000 'E. coli' coliformes por cada 100 mililitros. Además, los investigadores efectuaron análisis moleculares de la bacteria y confirmaron su resistencia a 22 de 23 antibióticos, incluyendo a los carbapenémicos de última generación.
Según Rosas Pérez, la escasez de agua en la zona semidesértica del Valle del Mezquital ha obligado a los lugareños a utilizar aguas residuales, tratadas y no tratadas para impulsar las actividades agrícolas.
Hasta hace poco se creía que las plantas de tratamiento eran el método más adecuado para reducir la carga bacteriana del agua y mejorar su calidad, sin embargo, se ha detectado que, en el tratamiento secundario, en los "lodos activados", se generan cultivos de bacterias donde estas se transmiten genes y se transforman.